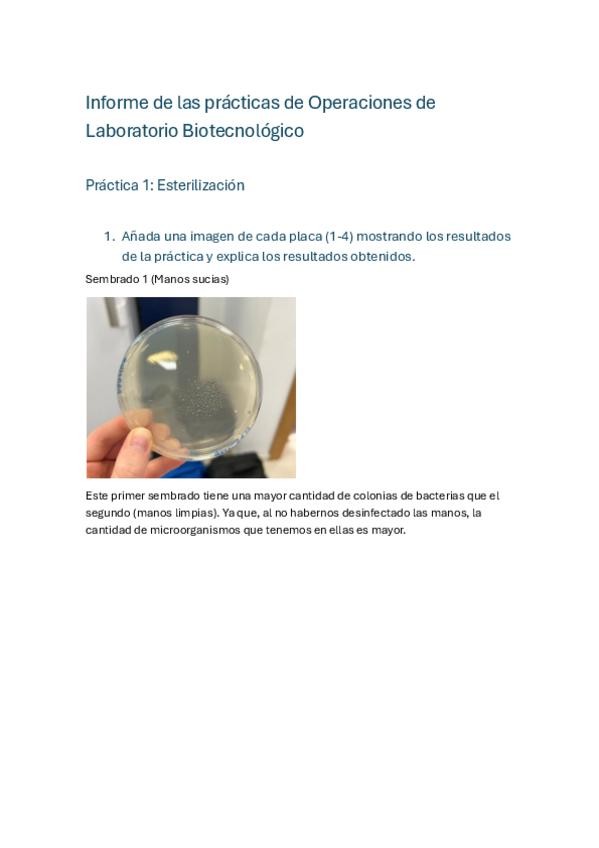

Operaciones de Laboratorio Biotecnológico
apuntes
-
1ª PARTE OLB
He publicado nuevos apuntes de 1º Operaciones de Laboratorio Biotecnológico: 1ª PARTE OLB
He publicado nuevos apuntes de 1º Operaciones de Laboratorio Biotecnológico: Seminario-5-Parte-I.pdf
He publicado nuevos apuntes de 1º Operaciones de Laboratorio Biotecnológico: Seminario-4-OLB-I.pdf
He publicado nuevos apuntes de 1º Operaciones de Laboratorio Biotecnológico: Seminario-3-OLB-Parte-I.pdf
He publicado nuevos apuntes de 1º Operaciones de Laboratorio Biotecnológico: Seminario-2-OLB-Parte-I.pdf
He publicado nuevos practicas de 1º Operaciones de Laboratorio Biotecnológico: Resumen-Practicas-OLB-Parte-I.pdf
apuntes
-
Apuntes OLB Parte 1
He publicado nuevos apuntes de 1º Operaciones de Laboratorio Biotecnológico: Apuntes OLB Parte 1
apuntes
-
Prácticas OLB Parte 1
He publicado nuevos apuntes de 1º Operaciones de Laboratorio Biotecnológico: Prácticas OLB Parte 1
apuntes
-
Apuntes OLB Parte 2
He publicado nuevos apuntes de 1º Operaciones de Laboratorio Biotecnológico: Apuntes OLB Parte 2
He publicado nuevos practicas de 1º Operaciones de Laboratorio Biotecnológico: Informe-practicas-OLB-Parte-2.pdf
He publicado nuevos apuntes de 1º Operaciones de Laboratorio Biotecnológico: Practicas-OLB-parte-1.pdf
He publicado nuevos apuntes de 1º Operaciones de Laboratorio Biotecnológico: Seminario-4-Acidos-Nucleicos.pdf
He publicado nuevos apuntes de 1º Operaciones de Laboratorio Biotecnológico: Seminario-3-Proteinas.pdf
He publicado nuevos apuntes de 1º Operaciones de Laboratorio Biotecnológico: Seminario-2-Cultivos-Celulares.pdf
He publicado nuevos apuntes de 1º Operaciones de Laboratorio Biotecnológico: Seminario-1-Esterilizacion.pdf
He publicado nuevos apuntes de 1º Operaciones de Laboratorio Biotecnológico: Seminario-4-Calculo-y-Medida-del-pH.pdf
He publicado nuevos apuntes de 1º Operaciones de Laboratorio Biotecnológico: Seminario-3-PREPARACION-DE-DISOLUCIONES-Y-CALCULOS-DE-CONCENTRACION.pdf
He publicado nuevos apuntes de 1º Operaciones de Laboratorio Biotecnológico: seminario-5-Cromatografia-y-PROCESOS-DE-SEPARACION.pdf
He publicado nuevos apuntes de 1º Operaciones de Laboratorio Biotecnológico: seminario-2-IDENTIFICACION-DEL-MATERIAL-BASICO-DE-UN-LABORATORIO-QUIMICO.pdf
He publicado nuevos apuntes de 1º Operaciones de Laboratorio Biotecnológico: seminario-1-seguridad-en-el-laboratorio.pdf
ejercicios
-
OLB
He publicado nuevos ejercicios de 1º Operaciones de Laboratorio Biotecnológico: OLB
He publicado nuevos apuntes de 1º Operaciones de Laboratorio Biotecnológico: Acidos-nucleicos.pdf
He publicado nuevos apuntes de 1º Operaciones de Laboratorio Biotecnológico: Proteinas.pdf
He publicado nuevos apuntes de 1º Operaciones de Laboratorio Biotecnológico: Cultivos-celulares.pdf
He publicado nuevos apuntes de 1º Operaciones de Laboratorio Biotecnológico: Esterilizacion.pdf
He publicado nuevos practicas de 1º Operaciones de Laboratorio Biotecnológico: Practicas-segunda-parte.pdf
apuntes
-
SEMINARIO 2 OLB FOTOS
Fotos de materiales de laboratorio para memorizar nombres
apuntes
-
Apuntes Completos Parte 2
He publicado nuevos apuntes de 1º Operaciones de Laboratorio Biotecnológico: Apuntes Completos Parte 2
He publicado nuevos ejercicios de 1º Operaciones de Laboratorio Biotecnológico: ejercicios-acido-base.pdf
conceptos basicos de extracciones liquido liquido y su procedimiento
apuntes
-
2 PARTE OLB COMPLETA: Seminarios y practicas
Esquema practicas
He publicado nuevos apuntes de 1º Operaciones de Laboratorio Biotecnológico: SEMINARIO-5-EXTRACCION-Y-CROMATOGRAFIA.pdf
He publicado nuevos apuntes de 1º Operaciones de Laboratorio Biotecnológico: SEMINARIO-4-pH-Y-DISOLUCIONES-REGULADORAS.pdf
He publicado nuevos apuntes de 1º Operaciones de Laboratorio Biotecnológico: SEMINARIO-3-PREPARACION-DE-DISOLUCIONES.pdf
He publicado nuevos apuntes de 1º Operaciones de Laboratorio Biotecnológico: SEMINARIO-2-MATERIAL-Y-OPERACIONES-BASICAS.pdf
He publicado nuevos apuntes de 1º Operaciones de Laboratorio Biotecnológico: SEMINARIO-1-SEGURIDAD-EN-EL-LABORATORIO.pdf
He publicado nuevos apuntes de 1º Operaciones de Laboratorio Biotecnológico: SEMINARIO-4-ACIDOS-NUCLEICOS-PURIFICACION-Y-ESTUDIO.pdf
He publicado nuevos apuntes de 1º Operaciones de Laboratorio Biotecnológico: SEMINARIO-3-PROTEINAS-PURIFICACION-Y-ESTUDIO.pdf
He publicado nuevos apuntes de 1º Operaciones de Laboratorio Biotecnológico: SEMINARIO-2-CULTIVOS-CELULARES.pdf
He publicado nuevos apuntes de 1º Operaciones de Laboratorio Biotecnológico: SEMINARIO-1-ESTERILIZACION.pdf
practicas
-
Resumen Prácticas - PARTE 1
He publicado nuevos practicas de 1º Operaciones de Laboratorio Biotecnológico: Resumen Prácticas - PARTE 1
apuntes
-
Apuntes Seminarios
He publicado nuevos apuntes de 1º Operaciones de Laboratorio Biotecnológico: Apuntes Seminarios
He publicado nuevos apuntes de 1º Operaciones de Laboratorio Biotecnológico: Esquemas-Seminario-1.pdf
He publicado nuevos ejercicios de 1º Operaciones de Laboratorio Biotecnológico: problemas-disoluciones-olb.pdf
He publicado nuevos ejercicios de 1º Operaciones de Laboratorio Biotecnológico: Problemas-ac-base-OLB.pdf
He publicado nuevos examenes de 1º Operaciones de Laboratorio Biotecnológico: examen-OLB-parte-1-oscar.pdf
apuntes
-
Seminarios parte 2
He publicado nuevos apuntes de 1º Operaciones de Laboratorio Biotecnológico: Seminarios parte 2
He publicado nuevos apuntes de 1º Operaciones de Laboratorio Biotecnológico: Como-resolver-problemas-OLB.pdf
He publicado nuevos apuntes de 1º Operaciones de Laboratorio Biotecnológico: Resumen-Parte-II.pdf
He publicado nuevos apuntes de 1º Operaciones de Laboratorio Biotecnológico: Practicas-OLB-segunda-parte.pdf
He publicado nuevos practicas de 1º Operaciones de Laboratorio Biotecnológico: Practicas-OLB-2a-parte.pdf
He publicado nuevos apuntes de 1º Operaciones de Laboratorio Biotecnológico: Apuntes-OLB-2a-Parte.pdf
He publicado nuevos apuntes de 1º Operaciones de Laboratorio Biotecnológico: Apuntes-OLB-1a-Parte.pdf
ejercicios
-
PROBLEMAS OLB 1ª PARTE
He publicado nuevos ejercicios de 1º Operaciones de Laboratorio Biotecnológico: PROBLEMAS OLB 1ª PARTE
He publicado nuevos practicas de 1º Operaciones de Laboratorio Biotecnológico: Cuestiones-Practicas-1oParte.pdf
ejercicios
-
Relaciones 1º Parte corregidas
He publicado nuevos ejercicios de 1º Operaciones de Laboratorio Biotecnológico: Relaciones 1º Parte corregidas
apuntes
-
Problemas OLB resueltos
He publicado nuevos apuntes de 1º Operaciones de Laboratorio Biotecnológico: Problemas OLB resueltos
examenes
-
Preguntas OLB parte 1 y 2 RESUELTAS
He publicado nuevos examenes de 1º Operaciones de Laboratorio Biotecnológico: Preguntas OLB parte 1 y 2 RESUELTAS